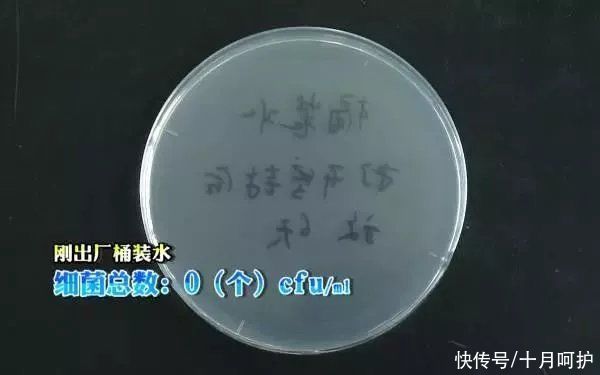
家用电器|家里细菌最多的竟是饮水机，感染家庭后悔知道太晚
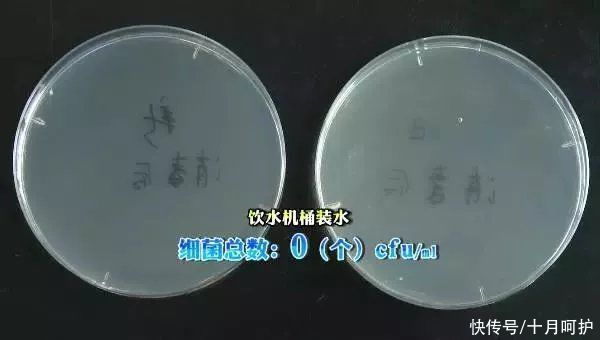
家用电器|家里细菌最多的竟是饮水机，感染家庭后悔知道太晚

菌菌之前做过一个小调查:各位家长觉得家里哪个地方最脏。
有人认为是马桶,也有人认为是油烟机,但大家都忽略了这个真正的“细菌王”:
饮水机!!!

文章插图
图源:网络
长时间不清洗的饮水机有多脏大家知道吗?
长这样:

文章插图
图源:新闻截图
让菌菌更惊讶的是,我们的很多家长没有清洗饮水机的习惯,只有百分之二十的表示会偶尔清洗。
1
【 家用电器|家里细菌最多的竟是饮水机,感染家庭后悔知道太晚】饮水机
长期不清洗有多脏?
很多家长觉得饮水机我们每天都在用,咋可能那么脏呢?
两组实验告诉你答案:
◆ 实验一:
实验人员先挑选了一款出厂5天的桶装水,对其出水口进行消毒并采集样本,发现此桶装水的细菌为0个/ml。
文章插图
图源:实验图片
随后又找到两台饮水机,一台为全新的,一台是用了三年,半年前清洗过的饮水机。
实验前又分别将两台饮水机清洗了一遍,最后放上桶装水,取样检测后发现两款饮水机的细菌总数都是0个/ml,说明两台饮水机里的水目前都没有被污染。
文章插图
图源:实验图片
然后把桶装水放在饮水机上静置6天后取样检测,结果发现这两桶水的细菌总数都大于1000个/ml。

文章插图
图源:实验图片
而《生活饮用水标准》GB5749-85规定:每100ml饮用水中的细菌总数不得超过100个。
很显然在饮水机上放置6天后的桶装水,已经完全达不到国家生活饮用水标准!
菌菌很难想象这么脏的水,如果孩子经常喝的话会怎样。
◆ 实验二:
实验人员打开一桶新的桶装水,这次并没有放到饮水机上,只是在桶口放了一个一次性杯子。
静置6天后,检测人员发现桶装水里的细菌含量依然是0个/ml,也就是说,加盖的桶装水由于几乎没有和外界接触,细菌无法进入,所以细菌数量没有增加。

文章插图
图源:实验图片
也就是说,饮水机就是导致桶装水细菌超标的罪魁祸首!
看到这里很多家长会好奇,饮水机为什么会让桶装水细菌超标这么严重?
这是因为,空气中的细菌只有吸附到某个平台后才会繁殖,而桶装水与饮水机的交界面,由于空气湿润,刚好给细菌的繁殖提供了理想环境。

文章插图
图源:宝宝呵护团队制作
很多家长觉得饮水机天天用,哪来的那么多细菌;也有家长抱有侥幸心理,想着不定期清洗也没关系。
但是通过上述实验大家也都看到了,长期不清洗的饮水机有多脏,孩子长期喝这样的水肯定会对身体造成不好的影响。
所以说饮水机一定要定期清洗!!!

文章插图
图源:宝宝呵护团队制作
那饮水机到底应该如何清洗?
多久清洗一次?
菌菌用最简单、最快捷的方法教你清洗饮水机。
2
最简单!
菌菌手把手教你清理
当饮水机内胆有滑腻手感,或者排水口出水出现水垢时,就说明饮水机需要清理了。
如果条件允许的话,最好每半个月或者一个月就清洗一次。
第一步:拔掉电源插头,取下水桶,用医用酒精蘸湿干净的抹布,清洁出水口、接水槽和饮水机外壳。
特别声明:本站内容均来自网友提供或互联网,仅供参考,请勿用于商业和其他非法用途。如果侵犯了您的权益请与我们联系,我们将在24小时内删除。
